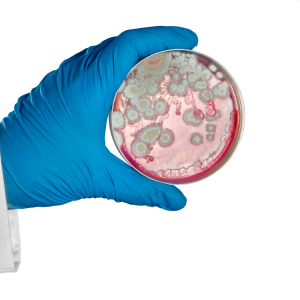
Mold Testing GA

Mold, a silent infiltrator, can quietly invade homes and businesses, causing not only structural damage but also posing significant health risks. In Macon, GA, where humidity levels can provide a conducive environment for mold growth, timely inspection and remediation are paramount.
This article will delve into the vital signs that necessitate immediate mold testing and inspection, particularly in the Macon GA area, and how professionals like KP Restorations can be your ally in ensuring a safe and mold-free environment.
Signs You Need Mold Testing in Macon, GA
Recognizing th Silent Invader: Mold
Visible Mold Growth
One of the most blatant signs that you require mold testing in Macon GA is visible mold growth. While small patches might seem manageable, they often indicate a larger, hidden issue. Mold can lurk in unseen areas, such as behind walls or under flooring, and visible mold is often the tip of the iceberg.
Persistent Unpleasant Odors
A musty or earthy odor, especially in damp areas like basements and bathrooms, is a telltale sign of mold presence. Even if mold is not visible, its distinct smell should not be ignored and warrants a thorough mold inspection.
Health Implications of Mold Exposure
Respiratory Issues and Allergies
Frequent respiratory problems, such as coughing, sneezing, and wheezing, can be a red flag for mold presence. Mold spores in the air can exacerbate allergies and asthma, making it crucial to seek professional mold testing services to safeguard your health.
Skin Irritations
Unexplained skin rashes, itchiness, or irritations, particularly among individuals with sensitive skin, can be attributed to mold exposure and should prompt an immediate inspection.
The Professional Approach to Mold Testing and Remediation
Comprehensive Mold Inspection
Embarking on a journey to ensure a mold-free environment begins with a comprehensive mold inspection, especially in areas like Macon, GA, where the climate can be conducive to mold growth. At KP Restorations, our meticulous mold inspection process is not merely a cursory glance at your property but a deep dive into all potential mold habitats, ensuring no spore is left undetected.
Our seasoned professionals utilize state-of-the-art equipment, such as moisture meters and infrared cameras, to identify hidden moisture sources and mold growth in less visible areas like behind walls, under flooring, and within ceiling cavities. Air and surface samples may also be collected and analyzed in a laboratory to determine the type and concentration of mold spores present, providing a clear picture of the extent and nature of the mold issue.
In addition to identifying existing mold, our team also investigates potential causes and contributing factors to mold growth, such as leaks, poor ventilation, and humidity control issues, to provide a holistic overview of your property’s mold situation. This thorough inspection allows us to formulate a tailored mold remediation plan, addressing not only the existing mold but also implementing strategies to prevent future occurrences.
In the realm of mold testing Macon GA residents can trust, KP Restorations stands out by ensuring that every inspection is exhaustive, accurate, and aimed at providing long-term solutions to maintain a healthy, mold-free environment in your property.
Effective Mold Remediation
Navigating through the complexities of mold remediation requires a strategic and scientifically-backed approach, particularly in the Macon, GA area, where specific environmental factors can influence mold growth. At KP Restorations, our mold remediation process is meticulously crafted to not only eradicate current mold infestations but also to implement preventative measures, ensuring long-lasting protection for your property.
Our effective mold remediation process unfolds in several pivotal stages:
– Containment: Initially, the affected area is isolated and contained to prevent the spread of mold spores to other parts of the property during the remediation process. Utilizing advanced containment procedures, such as negative air pressure and physical barriers, we ensure that mold spores are confined to the designated remediation area.
– Removal and Cleaning: Employing specialized equipment and adhering to industry-standard safety protocols, our team meticulously removes visible mold and cleans the area using EPA-approved antimicrobial agents. This step is crucial to eliminate mold at the source and safeguard against potential health risks.
– Air Filtration: High-efficiency particulate air (HEPA) filters are utilized to capture airborne mold spores and improve indoor air quality. This is vital to protect inhabitants from inhaling mold spores and to prevent them from settling in other areas, potentially causing new growth.
– Addressing Moisture Issues: Identifying and rectifying the root causes of moisture accumulation is pivotal to sustainable mold remediation. Our team conducts a thorough examination of potential moisture sources, such as leaks, condensation, and humidity, and implements corrective actions to mitigate these issues.
– Restoration: Depending on the extent of the mold damage, restoration may involve minor repairs, such as replacing drywall, or more extensive reconstruction. KP Restorations is adept at restoring your property to its pre-mold condition, ensuring structural integrity and aesthetic appeal.
– Preventative Strategies: Post-remediation, we provide clients with tailored strategies to prevent future mold growth. This may involve recommendations for improved ventilation, moisture management solutions, and regular maintenance checks.
In the realm of mold testing Macon GA residents and businesses can rely on, KP Restorations emerges as a beacon of expertise and reliability. Our comprehensive and effective mold remediation services are designed to restore the safety and integrity of your environment, ensuring that every nook and cranny is free from the perils of mold infestation.
Why Choose KP Restorations for Mold Testing in Macon GA
Expertise in Mold Inspection and Remediation
With extensive experience and a certified team, KP Restorations specializes in meticulous mold inspection, removal, and remediation, ensuring your environment is safe and healthy.
A Holistic Approach to Property Restoration
Beyond mold testing and remediation, we offer a suite of services, including water mitigation, water damage restoration, crawl space cleaning, and fire & smoke remediation, providing comprehensive solutions to protect and restore your property.
Conclusion
Mold can be a silent destroyer, gradually impairing the structural integrity of your property and adversely impacting health. Recognizing the signs and acting promptly with professional mold testing and inspection is vital to safeguarding your environment. KP Restorations, serving the Greater Macon, GA area, is committed to providing top-tier mold testing, inspection, and remediation services, ensuring your home or business is mold-free and secure.
Don’t let mold compromise your property and health. Contact KP Restorations, your local specialists in mold inspection, removal, and remediation, at (478) 200-5507. We are family-owned and dedicated to protecting and restoring your environment with our expert services.

